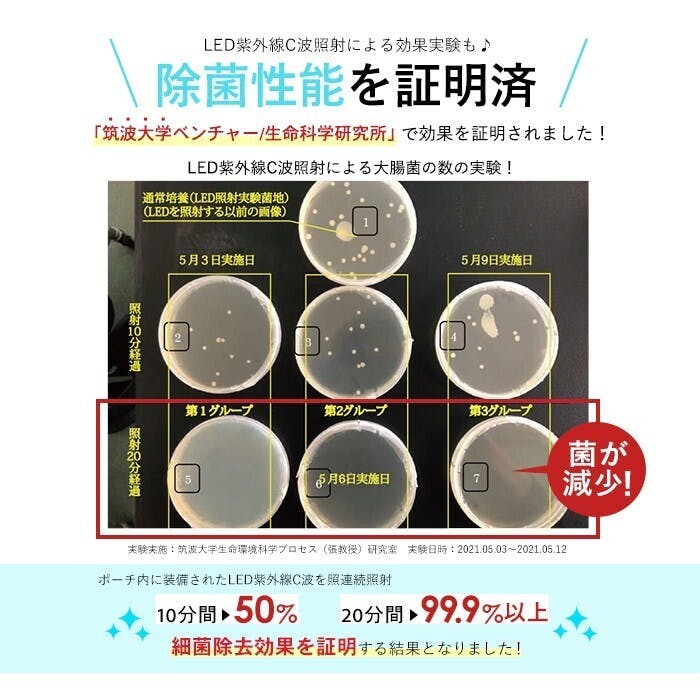

PURA BOX 20分で細菌とさよなら。小物を清潔に保てる毎日の新習慣
1941年、呉服小間物製造業として生まれた株式会社林吾
私達は、激動の戦後の生活様式の変化を経て、バッグ・財布・レザー小物の製造卸メーカーへと時代の変化に合わせて技術力を磨いてきました。
伝統技術である友禅や印伝を使ったブランド、素材にこだわったポニーレザーを使ったシリーズ展開など、継承すべき技術と長く使って頂ける上質な素材のシンプルなデザインを目指し、多数ブランド展開をおこなってきています。
そして、1974年にはグループ会社の株式会社ポームを設立し、刻々と変化するライフスタイルに寄り添う商品のご提案を行ってまいりました。国内外に生産拠点を持ち、展開する商品ラインナップをバッグ・財布・レザー小物からコンセプトを重視したアイテムやカスタムメイドのアイテムなどバラエティ豊富にし、さらにお客様のお手元へのお届け方法をネット通販に拡大してまいりました。
ポームで展開するバラエティに富んだブランドたち
しかし、2020年春、世界中が未曽有の災禍に見舞われ、これまでの生活は一変し、経済活動も著しく低迷しました。まだまだ先の見えない状況が続き、不安な日々が続いています。
感染の不安、自分から大切な人たちにうつしてしまうのではないかという不安。
様々な不安が取り巻く今の生活を少しでも安心して過ごせるように、何か手立てはないかと考える日々が続きました。

今の世の中に必要な安心とはなにか?
私達は、袋物の製造卸メーカーです。国内外で生産を行い、様々な商品を展開してきました。
これまでバッグや小物作りで培ってきた技術・ノウハウを活かして、世の中の役に立つ、世間に喜んでもらえるものを開発したい…そんな想いをカタチにできるよう今回のプロジェクトを立ち上げることにしました。
社内のスタッフそれぞれも、目に見えないウィルス、細菌の脅威、見えないからの不安は計り知れないと実感として持っていたため、手軽に除菌ができるとほんの少しは不安を和らげることができるかもしれない、と考えました。
そこで、除菌ができる紫外線ライトを内蔵したシンプルなポーチを企画することに。
未曽有の現状から、国内外で様々な大学や研究所が紫外線照射によるウイルス除去を研究しており、昨今ではその効果が認められています。
専用の機械は必要だけど、大掛かりなものは普段の生活には浸透しにくいものです。
生活に馴染んで手軽に活用できるように、できる限りシンプルにしてみました。

使い勝手はもちろん、身の回りの品を除菌できるマルチ紫外線除菌ライトを安全にご使用いただけるように計算されたデザインです。
アルコール除菌スプレーや除菌シートでは落とせない菌をUV除菌で99%の細菌を除去できます。

コロンとした可愛らしい形状とは裏腹に、20分で見事に除菌。
たったの20分でいいんです。
操作は簡単、ポーチの中に除菌したいものをいれ、ボタンを押すだけ!

これで20分後には除菌完了!
ちょっと用事を済ませている間に、除菌が完了。
その効果は、筑波大学ベンチャー㈱生命科学研究所にて実証済みです。
10分間照射で50%、20分間照射すると99.9%の細菌を除去できることが証明されました。
■検査実施機関名称:株式会社生命科学研究所
■検査地:筑波大学生命環境科学プロセス(張教授)研究室
■検査実施時期:2021年5月3日~2021年5月12日
■検査内容:
この実験は一般環境中の大腸菌を対象に行った。大腸菌が液体培養地における、成長状態が
対数増殖期(この時点は、大腸菌の活性が最も強大)になる時点で、菌液を希釈して、個体培養地
に移して滅菌実験を実施した。
①液体培地に培養した大腸菌が対数培養期に達する時点に、大腸菌の菌液を連続希釈し濃度を10 までとし100μLの菌液を個体培地に移植して実験を継続。
②対象検体を3グループに分けて同様試験法にて3グループの同レベルでの滅菌を確認。複数回の実験をする事により精度の高い結果証明となり偶然性の誤った結果も防げる。
■検査結果:
今回の被験体である滅菌機能ポーチ内に(通常環境/大腸菌)を上記の実験手法にて実験を実施、ポーチ内に装備された LED紫外線C波を照射10分間の連続照射で50%前後、20分間の連続照射でほぼ99.9%以上の滅菌機能の滅菌効果を証明する結果となった。
身の回りの日用品を安心して使いたい
では、どんなものが除菌可能なのでしょうか?
例えば、いつも持ち歩くお財布や革小物はもちろん、毎日長時間触れるスマートフォン、メガネやイヤホン、お出かけの際には必須となったマスク、ハンカチ、身に着けるアクセサリーや時計、大切な鍵など。
もしくは、会社や店舗では共有で使う文房具類だって除菌できたら嬉しいですよね。

家族で使う体温計も、テレビのリモコンも、いろんな人の手に触れるものは気になるという方も多いと思います。
歯ブラシや哺乳瓶、おしゃぶりなどの小さなお子様が、日常で口に触れるアイテムも。

女性には嬉しいメイク道具や綿棒だって、除菌できたら本当に安心。
また、活用シーンはキッチンでも。

布巾やお箸、スプーンや計量カップ、マグカップや水筒のコップなど、気になるものは入れておくだけで除菌してくれます。
持ち運びもらくらく。マイクロUSBでモバイルバッテリーでもチャージが可能です。
カフェでちょっと休憩中にも、マスクやスマホを除菌OK。
いつでもどこでも誰かが除菌している・・・そんな世界もすぐそこまで来ているかもしれません。
【商品詳細】
サイズ: 幅240×奥行195×高さ150㎜
重量:約 470g
素材:内側 アルミニウムプラスチックフィルム(Aluminum plastic film)
外側 ポリエステル
LEDライト数:12個
UV波長:260 ~ 280㎜
充電規格:USB対応(USBケーブル Type C)
ACアダプタ:入力・・・100~240V(50/60Hz 0.3A)
出力・・・5.0V(1A)
付属品:USB-ACアダプター、専用TypeC-USBケーブル
※PSEマーク取得済み




【リターンについて】
販売予定価格は、税込み7,920円を予定しております。
今回のプロジェクトへご支援いただける方へ、以下のようなリターンをご用意いたしました。
①【超早割】先着10名様 30%引き
Pura Box 1点 5,500円(税込)
②【早割】先着20名様 20%引き
Pura Box 1点 6,330円(税込)
③【感謝割】先着30名様 10%引き
Pura Box 1点 7,120円(税込)
■リターン品の発送について
・配送時期:2021年9月中旬ごろ
・配送元:国内配送 株式会社ポーム(ネットショップ イーモノより配送)
※商品の納期遅れのため予定日よりお届けが遅れる場合がございます。予めご了承ください。
※本プロジェクトはAll-in方式で実施します。目標金額に満たない場合も、計画を実行し、リターンをお届けします。
物づくりを通して、安心を届けたい。
今回のチャレンジは、私達にとって、大変大きな一歩です。
身の回りのものを持ち運ぶためのバッグというカテゴリから、皆さんの身の回りのものを除菌する為のポーチの開発。
物を運ぶためではなく、一人でも多くの方に少しでも安心して生活していただけるように。
良いものを創るのは、当然目指すべきところですが、その先に、皆さんの安心を担えるように。
これまでの取組みとは、異なる大きな一歩を踏み出してみよう。
そんな想いで、開発を続けてまいりました。
たくさんの方にご協力いただき、本プロジェクトをお披露目できるようになり、大変嬉しく思います。
PURA BOXを通して、おひとりでも多くの方に笑顔が届きますように。
■ 特定商取引法に関する記載
◯ 販売事業者名: 株式会社ポーム
◯ 事業者の所在地:〒537-0014 大阪府大阪市東成区大今里西 2-11-13
◯ 事業者の連絡先:Tel: 06-6976-0312 メール: support@e-mono.co.jp
※こちらでは当該製品に対するお申し込み、質問等は受け付けておりません。
◯ 商品の販売価格・役務の対価:各リターン記載のとおり
◯ 対価以外に必要な費用:プロジェクトページ、リターンに記載のとおり
◯ 申込期限:当ページ記載のプロジェクト終了期限どおり
◯ 代金の支払時期:
各プロジェクトが募集期間内に成立した時点で、支援金の決済が行われます。コンビニ払いは、コンビニエンスストアで所定の方法により支払いが完了した時点で、決済が行われます。銀行振込(ペイジー払い)は、ATMまたはネットバンキングにて所定の方法により支払いが完了した時点で、決済が行われます。auかんたん決済、ソフトバンクまとめて支払い・ワイモバイルまとめて支払い、ドコモ払い、PayPal、FamiPay、PayPayは、各決済画面により支払いが完了した時点で決済が行われます。
◯ 支払方法:
クレジットカード払い(Visa/Mastercard/JCB/Diners Club/American Express)/コンビニ払い(全国の主要コンビニエンスストア)/銀行振込(銀行ATM・ネットバンキング)/auかんたん決済/ソフトバンクまとめて支払い・ワイモバイルまとめて支払い/ドコモ払い/PayPal/FamiPay/PayPay。お支払いの手数料に関して、コンビニ払いの場合 350円(税込)が、お客様のご負担となります。また、銀行振込ご利用の場合は、所定の振込手数料がお客様のご負担となります。
◯ 商品引渡しまたは役務提供の時期:各プロジェクトが募集期間内に成立した場合のみ、支援金の決済が行われ、約定されたリターンを得る権利が発生します。なお、リターン毎の発送(履行)時期は各プロジェクトの記載・連絡に準じます。諸般の事情により遅延・遅配が生じる場合は、プロジェクトオーナーより記載・連絡されるものとします。
◯ キャンセル・返品: 利用規約記載のとおり、お客様都合による返品・キャンセルはできませんのでご注意ください。尚、製品到着後に破損や初期不良がある場合には交換させていただきますので「メッセージで意見や問い合わせを送る」から、または納品書記載の連絡先までお問い合わせください。
※上記以外の事項に関しては、お取引の際に請求があれば遅延なく提示いたします。






プロジェクト責任者の濱田と申します。リターンの掲載内容に少々不備がございました。USBケーブルが付属されないと記載してしまっておりますが、正しくはUSBケーブルおよびUSB-ACアダプターは標準で付属されておりますのでご安心くださいませ。皆様のご支援を心よりお待ち申し上げます。